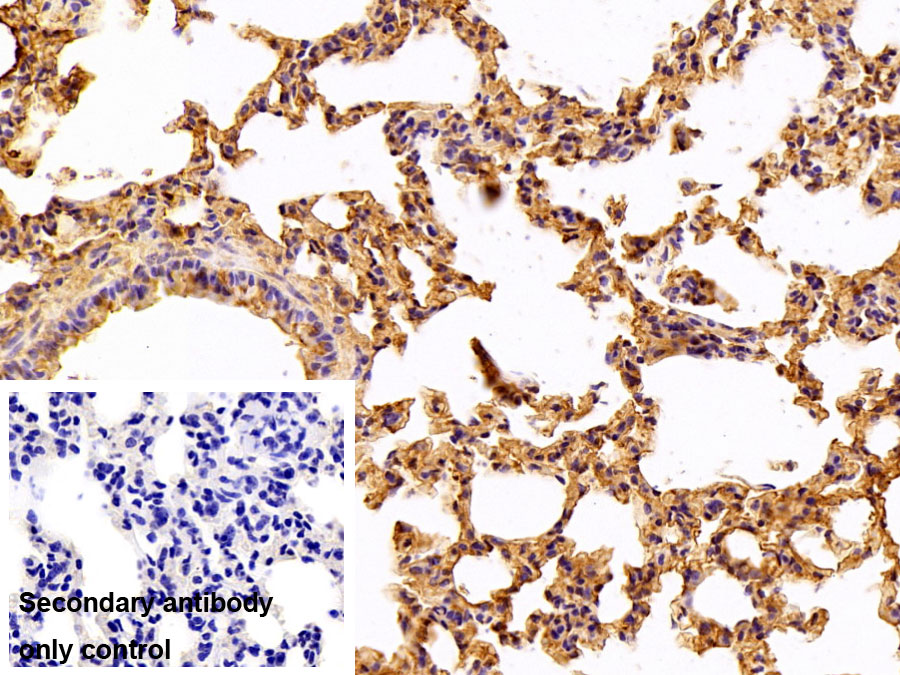

Polyclonal Antibody to Fibrinogen (FG)
F1; FI; Fbg; Coagulation Factor I
- Product No.PAA193Ra01
- Organism SpeciesRattus norvegicus (Rat) Same name, Different species.
- SourcePolyclonal antibody preparation
- HostRabbit
- Potencyn/a
- Ig Type IgG
- PurificationAntigen-specific affinity chromatography followed by Protein A affinity chromatography
- LabelNone
- Immunogen NPA193Ra01-Native Fibrinogen (FG)
- Buffer FormulationPBS, pH7.4, containing 0.02% NaN3, 50% glycerol.
- TraitsLiquid
- Concentration0.5mg/ml
- Organism Species MoreMus musculus (Mouse)
- ApplicationsWB; IHC
If the antibody is used in flow cytometry, please check FCM antibodies. - DownloadInstruction Manual
- UOM 20µl100µl 200µl 1ml 10ml
- FOB
US$ 103
US$ 239
US$ 342
US$ 855
US$ 3420
For more details, please contact local distributors!
SPECIFITY
The antibody is a rabbit polyclonal antibody raised against FG. It has been selected for its ability to recognize FG in immunohistochemical staining and western blotting.
USAGE
Western blotting: 0.01-2µg/mL;
Immunohistochemistry: 5-20µg/mL;
Immunocytochemistry: 5-20µg/mL;
Optimal working dilutions must be determined by end user.
STORAGE
Store at 4°C for frequent use. Stored at -20°C in a manual defrost freezer for two year without detectable loss of activity. Avoid repeated freeze-thaw cycles.
STABILITY
The thermal stability is described by the loss rate. The loss rate was determined by accelerated thermal degradation test, that is, incubate the protein at 37°C for 48h, and no obvious degradation and precipitation were observed. The loss rate is less than 5% within the expiration date under appropriate storage condition.
GIVEAWAYS
INCREMENT SERVICES
| Magazine | Citations |
| Chemical Research in Toxicology | Sub-chronic Toxicity and Cardiovascular Responses in Spontaneously Hypertensive Rats after Exposure to Multiwall Carbon Nanotubes by Intratracheal Instillation Pubmed:25580880 |
| Chemical Research in Toxicology | Subchronic Toxicity and Cardiovascular Responses in Spontaneously Hypertensive Rats after Exposure to Multiwalled Carbon Nanotubes by Intratracheal Instillation PubMed: 25580880 |
| VETERINARSKI ARHIV | Biomarkers of ketosis in dairy cows at postparturient period: acute phase proteins and pro-inflammatory cytokines doi: 10.24099/vet.arhiv.160126c |
| VETERINARSKI ARHIV | Biomarkeri ketoze u mliječnih krava u postpartalnom razdoblju: proteini akutne faze i proupalni citokini doi: 10.24099/vet.arhiv.160126c |
| Spike protein up-regulates inflammatory axis of both thromboinflammation and leukotriene in severe COVID-19 | |
| Toxicol Appl Pharmacol | CREB1 protects against the renal injury in a rat model of kidney stone disease and calcium oxalate monohydrate crystals-induced injury in NRK-52E cells 33421503 |
| large animal review | Influence of niacin application on inflammatory parameters, non-esterified fatty acids and functional status of liver in cows during early lactation |
| Catalog No. | Related products for research use of Rattus norvegicus (Rat) Organism species | Applications (RESEARCH USE ONLY!) |
| NPA193Ra01 | Native Fibrinogen (FG) | Positive Control; Immunogen; SDS-PAGE; WB. |
| PAA193Ra01 | Polyclonal Antibody to Fibrinogen (FG) | WB; IHC |
| PAA193Ra05 | Polyclonal Antibody to Fibrinogen (FG) | WB; IHC |
| MAA193Ra21 | Monoclonal Antibody to Fibrinogen (FG) | WB; IHC; ICC; IP. |
| SEA193Ra | ELISA Kit for Fibrinogen (FG) | Enzyme-linked immunosorbent assay for Antigen Detection. |
| LMA193Ra | Multiplex Assay Kit for Fibrinogen (FG) ,etc. by FLIA (Flow Luminescence Immunoassay) | FLIA Kit for Antigen Detection. |